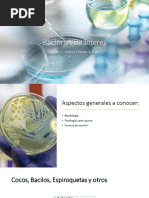

0% encontró este documento útil (0 votos)
58 vistas11 páginasMicrorganismos Patógenos en Enfermería
Este documento describe varias bacterias patógenas y las enfermedades que causan. Explica que las bacterias Staphylococcus aureus, Streptococcus pyogenes y streptococos pneumoniae causan varias infecciones como neumonía, meningitis y sepsis. Proporciona información sobre los síntomas, diagnóstico y tratamiento de las enfermedades causadas por estas bacterias.
Cargado por
jelitza guissell leiva aguilarDerechos de autor
© © All Rights Reserved
Nos tomamos en serio los derechos de los contenidos. Si sospechas que se trata de tu contenido, reclámalo aquí.
Formatos disponibles
Descarga como DOCX, PDF, TXT o lee en línea desde Scribd
0% encontró este documento útil (0 votos)
58 vistas11 páginasMicrorganismos Patógenos en Enfermería
Este documento describe varias bacterias patógenas y las enfermedades que causan. Explica que las bacterias Staphylococcus aureus, Streptococcus pyogenes y streptococos pneumoniae causan varias infecciones como neumonía, meningitis y sepsis. Proporciona información sobre los síntomas, diagnóstico y tratamiento de las enfermedades causadas por estas bacterias.
Cargado por
jelitza guissell leiva aguilarDerechos de autor
© © All Rights Reserved
Nos tomamos en serio los derechos de los contenidos. Si sospechas que se trata de tu contenido, reclámalo aquí.
Formatos disponibles
Descarga como DOCX, PDF, TXT o lee en línea desde Scribd